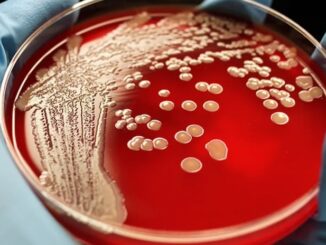
Super gonorrhea to be next pandemic out of China, CDC warns.

Australian Senate Vote To Establish Inquiry Into Excess Deaths
Thanks to the efforts of one very determined Australian senator, the Australian Senate has voted to establish a formal parliamentary inquiry into the nation’s excess deaths. It has taken more than a year but the […]